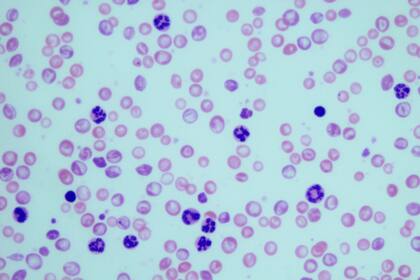
19/10/2022 Granulocitos en muestras sanguíneas de ratones con leucemia mielogénica crónica. ESPAÑA EUROPA MADRID SALUD CSIC

Una nueva técnica con células CAR-T logra la remisión de un tipo de leucemia fatal en dos adolescentes
Un estudio realizado por investigadores del Great Ormond Street Hospital (Reino Unido) ha logrado la remisión de un tipo de leucemia fatal -leucemia linfoblástica aguda (LLA) de células T en recaída- en dos adolescentes, gracias a una nueva técnica que consiste en el uso de la edición genética mediante la terapia CAR-T.
Utilizaron la edición para generar células T receptoras de antígenos quiméricos (CAR) universales y listas para usar. Se transdujeron células T de donantes voluntarios sanos con el uso de un lentivirus para expresar un CAR con especificidad para CD7 (CAR7), una proteína que se expresa en la leucemia linfoblástica aguda de células T.
Luego usaron la edición de bases para inactivar tres genes que codifican los receptores CD52 y CD7 y la cadena B del receptor de células T aB para evadir la seroterapia que agota los linfocitos, el fratricidio de células T CAR7 y la enfermedad de injerto contra huésped, respectivamente. Investigamos la seguridad de estas células editadas en tres niños con leucemia recidivante.
El primer paciente, una niña de 13 años que había recaído en LLA de células T después de un alotrasplante de células madre, tuvo una remisión molecular dentro de los 28 días posteriores a la infusión de una dosis única de CAR7 con base editada (BE-CAR7). Después recibió un alotrasplante de células madre de intensidad reducida (no mieloablativo) de su donante original, con reconstitución inmunológica exitosa y remisión leucémica en curso.
Las células BE-CAR7 del mismo banco mostraron una potente actividad en otros dos pacientes y, aunque en un paciente se desarrollaron complicaciones fúngicas fatales, el otro paciente se sometió a un alotrasplante de células madre mientras estaba en remisión. Los eventos adversos graves incluyeron síndrome de liberación de citocinas, citopenia multilinaje e infecciones oportunistas.
Los investigadores señalan que los resultados provisionales de este estudio de fase 1 respaldan una mayor investigación de las células T editadas en base para pacientes con leucemia recidivante e indican los riesgos anticipados de complicaciones relacionadas con la inmunoterapia.
El estudio, que comenzó en enero 2022 y espera cerrarse en septiembre 2024, trata a niños de 6 meses a 16 años con leucemia de células T que ha reaparecido (recaído) después de la quimioterapia o que no responde a la quimioterapia (refractario).
La leucemia de células T es un tipo poco común de cáncer de células sanguíneas que afecta a los glóbulos blancos (células T). La terapia celular se elabora a partir de glóbulos blancos (células T) recolectados de un donante sano y modificados para que puedan destruir otras células T, incluidas las células leucémicas.
Estas células CAR T 'prefabricadas' se han creado utilizando una nueva técnica llamada edición de base CRISPR para modificar su código de ADN y se les ha dado el nombre BE CAR-7. Esta técnica les permite trabajar después de la quimioterapia y además los desarma para prevenir efectos contra las células normales.






